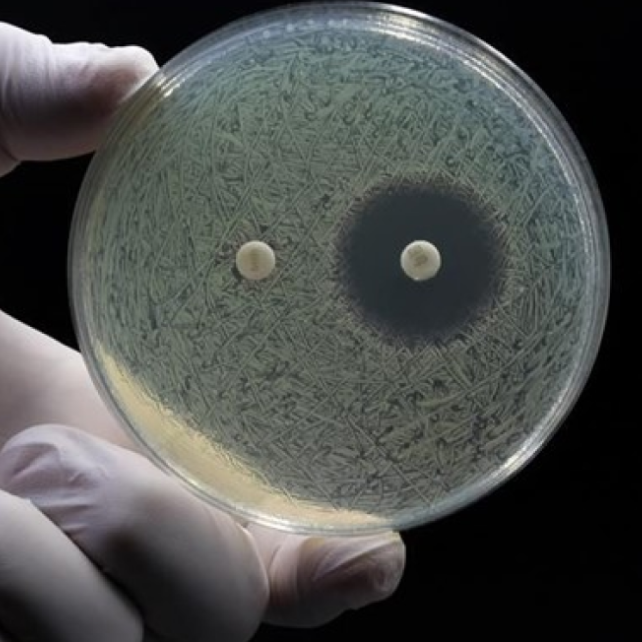
Historic Discovery Reveals New Weapon Against Drug-Resistant

マイストア
変更
お店で受け取る
(送料無料)
配送する
納期目安:
2025.12.05 21:33頃のお届け予定です。
決済方法が、クレジット、代金引換の場合に限ります。その他の決済方法の場合はこちらをご確認ください。
※土・日・祝日の注文の場合や在庫状況によって、商品のお届けにお時間をいただく場合がございます。
Bacteria 1708 リドレイドワーフまとめ買い Bacteria 1708 リドレイドワーフまとめ買い Bacteria 1708 リドレイの詳細情報
Bacteria 1708 リドレイドワーフまとめ買い Bacteria 1708 リドレイ。Bacteria 1708 リドレイドワーフまとめ買い Ridleyi silver dwarf 前葉。Historic Discovery Reveals New Weapon Against Drug-Resistant。台湾の有名ナーサリー、黃源の花草空間さんのビカクシダ バクテリアのスポアになります!※ナーサリータグ付きバランスも良く、根もしっかりはっております!板付けには十分なサイズ感だと思います!多分岐で見応えのあるスーパードワーフをぜひご検討ください!—•—•—•—•—•—•—•—•—•—•—•—•—•—•—•—•—発送方法は第四種郵便を使用します!メルカリ便に変更は+500円速達は+400円で、変更可能です!※購入前にコメントかDMでご連絡ください!メルカリのシステム上、購入後の変更ができません!また、コメントしていただいても先にご購入いただいた方が優先となってしまいます。Bacterial Infection | The Scientist。
ベストセラーランキングです
近くの売り場の商品
カスタマーレビュー
オススメ度 4.6点
現在、5606件のレビューが投稿されています。